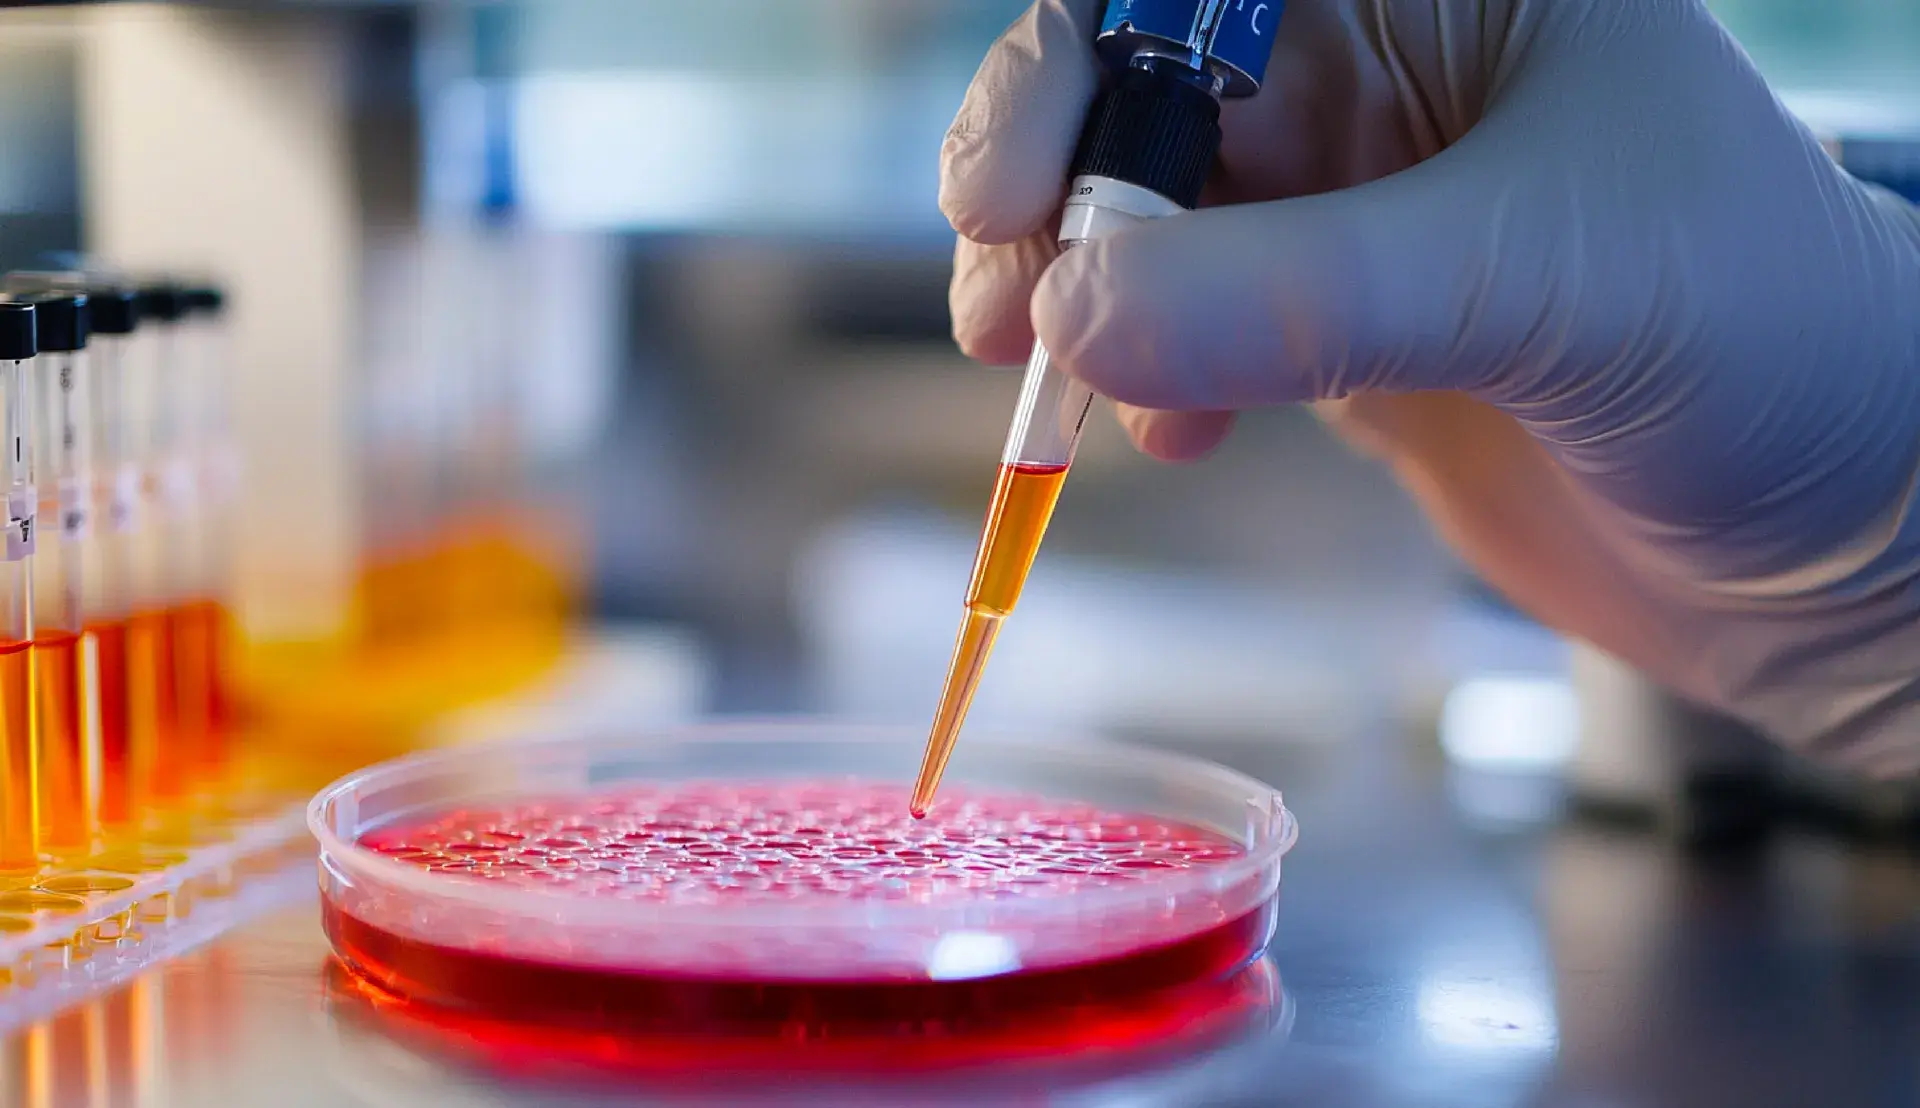

Laboratorio
Estándares que inspiran confianza
- ISO 9001: sistema de gestión de calidad aplicado a la obtención de concentrados de células madre mesenquimales de cordón umbilical.
- ISO 13022: gestión de riesgos para productos con células humanas viables.
- ISO 14644: clasificación y control de la limpieza del aire en salas limpias.
- ISO 22859: requisitos para biobancos de MSC derivadas de tejido de cordón umbilical.
Además, somos parte del ecosistema científico internacional en terapia celular, reforzando nuestro compromiso con la investigación y la innovación.
Ubicación privilegiada, experiencia integral
Pereira es un destino seguro y conectado, ideal para quienes buscan combinar bienestar con una estadía agradable: pueblos cafeteros vibrantes, paisajes espectaculares y servicios de salud de alto nivel en un mismo lugar.
Razones para elegir Regencord
Expertos en medicina regenerativa
Nuestro equipo de especialistas en terapia celular proporciona una atención excepcional, garantizando el más alto nivel de experiencia en medicina regenerativa.
Innovación
Estamos comprometidos con el avance continuo de nuestros tratamientos para ofrecer los mejores resultados posibles.
Seguridad
Nos adherimos a las normas y protocolos más estrictos, garantizando que cada tratamiento sea seguro y eficaz.
Ubicación privilegiada
No sólo ofrecemos terapias celulares avanzadas, sino también el mejor café. Experimenta un viaje seguro y agradable rodeado de una gastronomía excepcional y de gente cálida y acogedora.
Calidad
Nos dedicamos a la excelencia, ofreciendo tratamientos de alta calidad basados en una investigación científica rigurosa y en la experiencia clínica.
Atención personalizada
Tu privacidad es nuestra máxima prioridad. Proporcionamos un entorno discreto y seguro, salvaguardando tu espacio personal y tu información.
Servicios adicionales
Tratamientos relacionados
Cerebro y médula espinal
Acelera la recuperación neurológica con nuestras ...
Articulaciones
Recupera la movilidad y alivia el dolor gracias a ...
Envejecimiento
El síndrome de fragilidad se caracteriza por una ...
Deportes
Acelera tu recuperación y aumenta tu rendimiento ...
Belleza
Consigue una piel más sana con nuestros ...
Autoinmune
Equilibra y modula tu sistema inmunológico con ...
Sexo y reproducción
Mejora tu rendimiento, aumenta tu fertilidad y ...
Órganos y tejidos
Mejora el funcionamiento de los órganos al ...